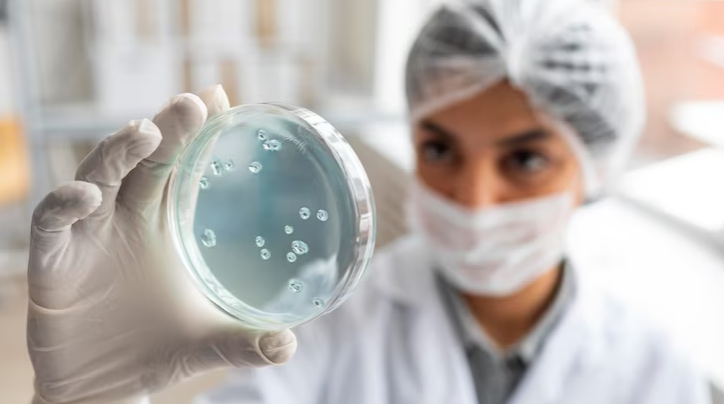

Izabella Thaís da Silva – Departamento de Ciências Farmacêuticas – Universidade Federal de Santa Catarina (UFSC)
Você já ouviu falar que os vírus podem ser nossos aliados na luta contra o câncer? Acredite ou não, a pesquisa médica está explorando essa ideia.
Vamos explicar de uma maneira mais simples.
O efeito antitumoral da infecção viral natural em pacientes com câncer não é nenhuma novidade. Recentemente, por exemplo, foi relatado que um homem de 61 anos, na Inglaterra, com Linfoma de Hodgkin em estágio III (um câncer no sistema linfático) teve remissão da doença após ser infectado pelo novo coronavírus (veja o estudo completo AQUI).
O mesmo efeito já havia sido constatado pela medicina há mais de um século, porém, somente nos últimos anos, os avanços científicos permitiram a elucidação de como os vírus oncolíticos (ou seja, os vírus capazes de matar as células tumorais) funcionam e interagem com o sistema imunológico. Sabe-se que os vírus naturalmente possuem uma capacidade inata de eliminar células cancerígenas, porém para otimizar o seu potencial oncolítico, são necessárias alterações para melhorar a sua seletividade pelas células cancerígenas e diminuir a sua toxicidade.
Continuar lendo